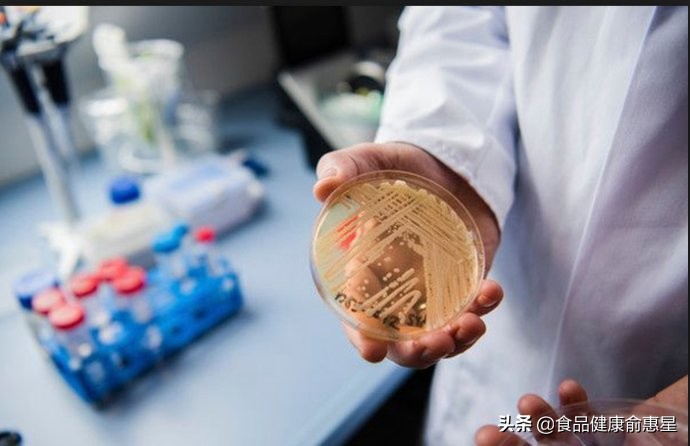
真菌居然长得如此逆天,超级真菌会蔓延全世界么
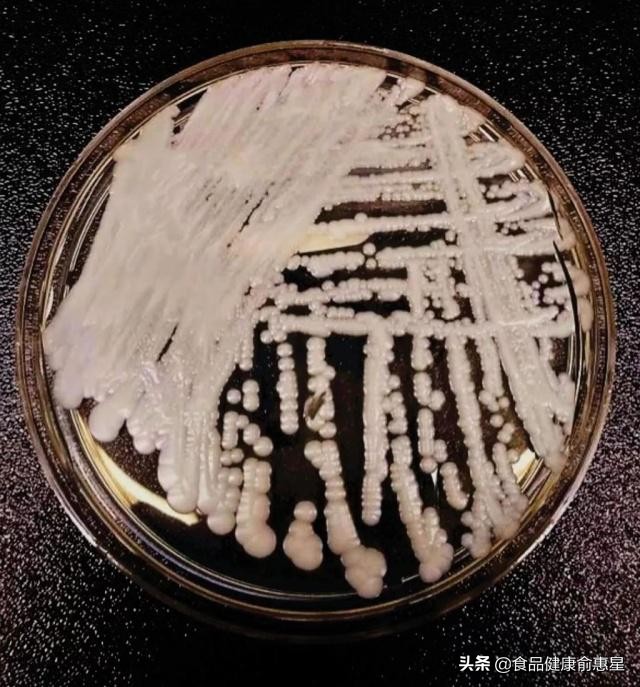
真菌居然长得如此逆天,超级真菌会蔓延全世界么

“美国超级真菌爆发 致死率60%”
“超级真菌被美列为紧急威胁 中国已有18例确认感染”
这些刷屏标题吓人不?
但股市分明是被激着了
“超级真菌概念股”应运而生。
尽管被“概念”的上市医药公司还云里雾里
但股民已血脉偾张
段子也已起舞飞扬:
上市公司:
公司不存在应披露而未披露的重大信息。
股民:
不,你应该有。
上市公司:
我们尚未有针对“超级真菌”的特效药品。
股民:
闭嘴,说你有你就有!
不管怎么说
“超级真菌”确实来了
但它真的超级无敌吗?
图源/网络
“超级真菌”的真名叫耳念珠菌
属于真菌中的念珠菌属。
因为该菌具有多重耐药和致死率高的特征
犹如对多种抗生素耐药的“超级细菌”
故称 “超级真菌” 。
尽管美国疾病控制与预防中心(CDC)
于近日将耳念珠菌列入“紧急威胁”名单
实际上
早在10年前的2009年
“超级真菌”就在日本被发现。
耳念珠菌
念起来是不是有些拗口?
别着急。
先来看念珠菌:
它是常见的条件致病菌
比如白色念珠菌就能引起妇科疾病。
由于念珠菌菌体有着念珠一般的形状
故得名念珠菌。
由于耳念珠菌最早是在一名日本患者的
外耳道分泌物中首次发现
故得名耳念珠菌。
是不是很形象?
耳…念珠菌
现在是不是顺口了些?
培养皿中的耳念珠菌菌株。图源/美国CDC官网
耳念珠菌具有以下一些特点:
是一种新近进化出来的新物种
高度耐药或多重耐药;
该菌全球范围内流行
可散发出现
亦可院内爆发流行
能长时间存活于
患者和医护人员的皮肤及医院设施表面
这里的院内是指医院或医疗机构;
耳念珠菌可引起血液感染甚至死亡
致死率高达60%。
国外接踵而来的消息更渲染了人们担忧的气氛:
全美感染病例已上升到587宗
近50%的感染者在90天内身亡;
全球至少30个国家已有临床感染病例报道
共计病例617例;
2018年在英国爆发的超级真菌感染,
祸首就是一只共用的体温计……
研究表明
耳念珠菌可能存在多个独立起源
在不同大陆具有不同的遗传特性
全球存在至少4个进化分支
这表明耐药性是同时在世界各地独立进化的。
国内的研究也证实了这一点。
真菌学国家重点实验室黄广华研究员
和北京大学人民医院王辉教授的团队合作研究
报道了中国首例“超级真菌”感染病例
此感染发生在2018年
分离自一位76岁的患者。
据黄广华介绍
中国“超级真菌”临床感染病例报告
延迟的主要原因
可能是技术问题
传统的生化鉴定方法很难鉴定“超级真菌”
目前主要使用
质谱技术和分子生物学方法这两种。
“质谱仪在中国大三甲医院以外并不十分普遍
不排除漏检的可能。”
换句话说
2018年可能并不是我国“超级真菌”致病元年。
研究发现
与多个国家报道的多重耐药菌株不同
中国第一株“超级真菌”菌株BJCA001
对临床上常用的抗真菌药物普遍比较敏感
这意味着
医生可以根据耐药性检测报告
选择相应药物对抗“超级真菌”。
“超级真菌”并非处处超级无敌!
研究还发现
硫酸铜对“超级真菌”具有很强的生长抑制效果
这为院内感染防治提供了新途径。
好消息还有
耳念珠菌对健康人不会造成太大的影响!
中国累计发现18例感染者
其中北京3例,沈阳15例
感染者多出现在医疗机构的ICU
(重症监护室)。
黄广华解释说
耳念珠菌感染主要发生医院内
集中在免疫力低下的人群
如ICU病房。
“常规消毒很难消除耳念珠菌
与携带者或感染者共用医疗器械
易造成感染。”

图源/网络
美国的大规模流行也都是在院内发生。
免疫系统不成熟或受损的人最容易中招
“对健康人群没有什么影响,也不需要预防。”
黄广华还提醒说:
“耳念珠菌没有孢子,不会通过空气传播。”
因此
正常人不应过度担忧“超级真菌”
有时候担忧往往源于不了解。
中国工程院院士廖万清教授也指出:
“从目前监测结果来看
中国出现耳念珠菌爆发性流行的可能性较低。”
中国疾控中心龚杰博士则认为
长期以来
真菌感染受关注度较低
许多医疗单位诊断和鉴定真菌的能力不是很强
可能存在误诊或漏诊。
那么
“超级真菌”的出现
从另一个角度似乎也在提醒
医疗机构要加强防控
提升检测设备
提高检测手段
规范消毒流程
制定应急预案
战术上重视“超级真菌”和真菌感染
才是“超级真菌”带给我们的又一鼓励。
——作者俞惠星,著有《活着要懂添加剂》
参考资料:
梁官钊 吴绍熙 郭宁如 刘维达.中国耳念珠菌.中国真菌学杂志.2018.10.13(5)
科技部网站.真菌学国家重点实验室在“超级真菌”感染的防治方面取得新进展
中国新闻周刊.超级真菌被美国列为“紧急威胁”,中国已有18例确认感染
科技日报.专家:“超级真菌”来自哪里?攻击谁?会暴发吗?